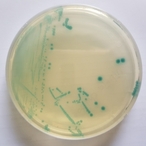

-

경기도, 택시 청결상태 합동 점검…거부 시 과징금 부과
- 2018-05-03 00:01
- 강한별 기자
-

경기도북부소방재난본부, 화재안전특별조사요원 45명 공모
- 2018-05-02 23:58
- 강한별 기자
-

2016년 중단된 안산 꽃 축제, 경기도 규제개선 건의로 재개 길 열려
- 2018-05-02 23:55
- 강한별 기자
-

경기도, 북부2차 테크노밸리 타당성 조사의뢰…본격 행정절차 착수
- 2018-05-02 23:52
- 강한별 기자
-

경기도내 올해 첫 비브리오패혈증균 검출…감염병 주의해야
- 2018-05-02 23:50
- 강한별 기자
-

경기도 신품종·신기술, ‘2018 서울국제식품산업대전’서 선보인다
- 2018-05-02 23:44
- 강한별 기자
-

‘경기도 생태텃논’에 여러분을 초대합니다
- 2018-05-02 23:41
- 강한별 기자
-

유니콘 꿈꾸는 청년 스타트업, 슈퍼맨 창조오디션에 도전하라
- 2018-05-02 23:34
- 강한별 기자
-

경기도 시장개척단, 한-중미FTA 타고 3,352만 달러 수출상담
- 2018-05-02 23:32
- 강한별 기자
-

경기 김포 구제역 이동제한 해제…방역은 지속
- 2018-05-02 23:27
- 강한별 기자
-

경기도 황해경제자유구역(평택 BIX), 중견기업의 차세대 리더와 협력기회 마련
- 2018-05-02 23:25
- 강한별 기자
-

경기도 지원 연구진, 차세대 항결핵제 인공 합성 기술 세계 최초 성공
- 2018-05-02 23:22
- 강한별 기자
-

경기도, 고양시 공동주택 리모델링 기본계획 승인…리모델링 본격화 전망
- 2018-05-02 23:18
- 강한별 기자
-

경기도, 이천 SK하이닉스 인근 4만㎡규모 기업형임대주택 지구 지정
- 2018-05-02 23:16
- 강한별 기자
-

‘가구 대·중소기업 간 공급자박람회’로 동반성장 기회 잡으세요!
- 2018-05-02 23:13
- 강한별 기자
- 1 경기도교육감 민주진보 단일후보를 내기 위한 선거인단 가입 돌입
- 2 [인터뷰] 유은혜 “경기교육, 다시 기본으로…‘숨 쉬는 학교’ 만들겠다”
- 3 유은혜 경기도교육감 예비후보, AI 교육 현장 전문가와 간담회…‘미래교육 방향 논의’
- 4 부천시 춘의종합사회복지관, 지역주민과 함께하는 “춘의작은음악회” 개최
- 5 고양시 덕양구, ‘고양콘’ 앞두고 축제 분위기 조성 총력
- 6 오산시, 봄맞이 '2026 오산천 벚꽃 축제' 개최
- 7 화성특례시, 고유가 대응 '민생안정 지역화폐 캐시백' 4월 시행
- 8 경기도의회 김재훈 의원, 저출산 해법, 지역사회 돌봄에서 시작
- 9 경기도, 평화경제특구 유치 위한 ‘전략적 후보지’ 확정
- 10 경기도, '언제나 어린이집' 이제 간편하게 온라인으로 신청하세요
리버럴미디어
| 본사: 경기도 수원시 팔달구 경수대로466번길 58 455호
| 오산지사: 경기도 오산시 남부대로 446, 2층
| 등록번호 경기 아51552 | 등록일자 2017년 5월 12일
| 발행인 공소리 | 편집장 공소리 | 청소년보호책임자 공소리
| 제보·광고문의 전화 070-4571-6619, 팩스 050-4280-9732, 휴대폰 010-9364-0527
| E-mail : sori_voice@liberalmedia.co.kr
「열린보도원칙」 당 매체는 독자와 취재원 등 뉴스이용자의 권리 보장을 위해 반론이나 정정보도, 추후보도를 요청할 수 있는 창구를 열어두고 있음을 알려드립니다.
고충처리인 공소리 070-4571-6619 sori_voice@liberalmedia.co.kr